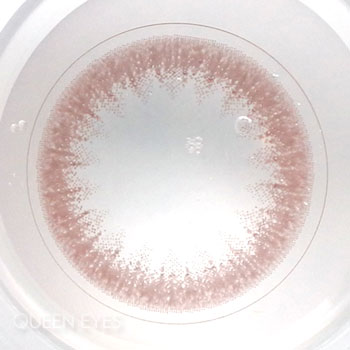

【レポ】eRouge(エルージュ) クラリティブラウン、自然だけどしっかり印象も変わるピンク系ナチュラルカラコン

| 枚数 | 1箱6枚入り |
|---|---|
| 価格 | ¥2,420(税込) |
| 使用期間 | 2週間 |
| 度数 | ±0.00~-8.00 |
| 直径 | 14.1㎜ |
| BC | 8.7㎜ |
-
度なし・度あり
商品ページへ
今回は大屋夏南さんがモデルをしている『eRouge(エルージュ)』の「クラリティブラウン」を紹介したいと思います。このカラコンは2週間カラコンでデザインもナチュラルなものが多く1日約57円とコスパも良いため普段使いにぴったりです。
まずはレンズのレポから
レンズを見た感じは、薄いブラウンに少し淡いピンク色が感じられる色味をしています。ドットがかなり細かくデザインされています。繊細なデザインがとても綺麗です♡
1番外側がかなり粒の細かいドットで描かれており、このドットのおかげでうまく瞳に馴染んでくれそう。ここまで細かいドットのフチのカラコンは無かった気がします。内側はドットを潰したような絶妙なデザインになっています。

色素の薄いカラコンでよくある、黄色に近い茶色ではなくピンク系の色素の入った薄い茶色です。このような色のカラコンはあまり見たことがないかもしれません。
クラリティブラウンを着けてみます
直径が14.1mmでデザインも薄めの茶色が使われているので、かなりナチュラルです。カラコン着けていることはバレにくいと思います。クリアレンズの瞳と比べると印象が優しくなったかな?という感じはしますが、サイズが大きめのカラコンのような大きな変化はありません。
フチのドットが白目とうまく馴染んでくれているので、まるで元から色素が薄い瞳のようです!直径も大きすぎないのでかなりナチュラルです!写真では分かりずらいかもしれませんが、ちょっと赤みを感じられる瞳になるので、甘めの印象になります。

あまり変化は感じられません。カラコンをつけていることをバレたくないけどもう少し瞳を少し色素の薄い色にしたいという人にぴったりだと思います!かなりナチュラルですが、ピンクっぽい色でカラコンを着けていることは分かるかもしれません。
クラリティブラウンを両目に装着
クリアレンズと比べると印象が優しくなったと思います。大きさもデザインもかなりナチュラルなので、今まで直径が大きめのしっかり大きな瞳になるカラコンを着けていた人は少し物足りなさを感じてしまうかもしれません。ほんのりピンク色なので甘めの服を着る方や、赤みのある髪色をしている方は特によく似合いそう。

色が明るいため顔がパッと明るくなります。この距離だとカラコンしてるのがかなり分かりずらいです!ナチュラルカラコンですが、赤みがあるためすっぴんよりはメイクしたほうがよく馴染むと思います!
エルージュ クラリティブラウン
まとめ
- ピンクブラウンでふわっとした雰囲気になれる
- かなりナチュラルだけどピンク色でバレるかも
- サイズ小さめ、フチもぼかしてるので小さく感じる
こんな人におすすめ
- 色素の薄いカラコンで少し甘めの顔になりたい
- 印象は変えたいけどいかにもカラコンっぽいのは嫌だ
- ピンク系の髪色・ファッション・メイクをすることが多い
色素の薄いカラコンの中でもかなりナチュラルですが、しっかり印象も変わっているのでいいとこどりのカラコンだなと思いました!ピンク系で少し甘めの顔になるのでデートのときにおすすめです。
最終更新日:
| 枚数 | 1箱6枚入り | 着色直径 | 13.4mm |
|---|---|---|---|
| 価格 | ¥2,420(税込) | BC | 8.7mm |
| 使用期間 | 2週間 | 含水率 | 38.6% |
| 度数 | ±0.00~-8.00 | モイスト | なし |
| DIA | 14.1㎜ | UVカット | なし |
2週間カラコンレポ
人気ランキング
-
1

- 度あり・なし
- ±0.00~-10.00
- 14.0mm
- 2week
【レポ】ラルム2weekシリコーン ミルキーウェイミニ。グッと控えめになった色素薄い系!透明感は↑↑↑
-
2

- 度あり・なし
- ±0.00~-10.00
- 14.0mm
- 2week
【レポ】ラルム2weekシリコーン クリアマカロンミニ。とろんとまろやかな発色×高スペックが最先端!
-
3

- 度あり・なし
- ±0.00~-10.00
- 14.0mm
- 2week
【レポ】ラルム2weekシリコーン ビューティーブラウンミニ。元の良さは残しつつ大人っぽくパワーアップ!
-
4

- 度あり・なし
- ±0.00~-10.00
- 14.0mm
- 2week
【レポ】ラルム2weekシリコーン ハニースウィートミニ。大人気カラーを最高の着け心地にパワーアップ!
-
5

- 度あり・なし
- ±0.00~-10.00
- 14.0mm
- 2week
【レポ】2weekアーティラルUV&Moist オークル。裸眼っぽく瞳をワントーンアップ↑
このカラコンの値段・スペック
枚数
1箱6枚入り
価格
¥2,420(税込)
使用期間
2週間
度数
±0.00~-8.00
直径
14.1㎜
BC
8.7㎜
この商品の口コミレビュー評価
全87件
このレポで紹介したカラコンは
ここから買えるよ♪
あなたが最近チェックしたレポ
このレポを見た人はこのレポも見ています

【レポ】eRouge(エルージュ) フレアブラウン。抜け感のあるフチでナチュラルな瞳に。立体感と輝きをプラスしてお洒落な印象をGET☆

【レポ】eRouge(エルージュ) ベージュオンブル。ほんのり色素を薄く!抜け感のある瞳でこなれた感アップ♪

【レポ】eRouge(エルージュ) ルシールオークル。繊細なギザギザ模様で瞳に立体感。落ち着いたリッチな雰囲気に。

【レポ】eRouge(エルージュ) スムースブラウン。瞳本来のツヤ感が活かされる!ちゅるんとした瞳が可愛い♡

【レポ】eRouge(エルージュ) シックブラウン。チョコカラーが瞳に溶け込む!生まれつき大きな瞳のよう…♡

















